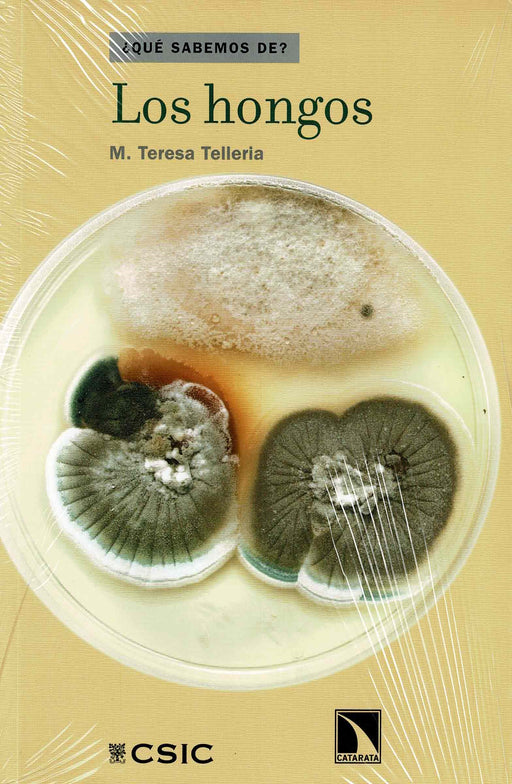

en pedidos superiores a 49,95€
Filtros
ECOLOXÍA E MEDIO AMBIENTE. HOME E NATUREZA
-

AGRICULTURA REGENEERATIVA
FONT ROVIRA, FRANCESC€35,00| /La agricultura regenerativa es una metodolog¡a que aglutina una variedad de técnicas de cultivo innovadoras que comparten un objetivo común: restab...
Ver todos los detalles€35,00| / -

LOS BACTERIOFAGOS LOS VIRUS QUE COMBATEN INFECCIONES
VV. AA.€12,00| /La diversidad del mundo microbiano incluye bacterias beneficiosas y bacterias patógenas. Las segundas producen infecciones en humanos y animales,...
Ver todos los detalles€12,00| / -

ATLAS CLASIFICATORIO DE LA FLORA DE ESPAÑA PENINSULAR Y BALEARES. VOL: II
GARCIA ROLLAN, MARIANO€25,00| /Tercera edición, corregida, del segundo y último volumen de un atlas de flora que incluye miles de ilustraciones acompañadas de una clave propia, s...
Ver todos los detalles€25,00| / -

EN BUSQUEDA DE LAS ESPECIAS
Ramón Morales€22,00| /En la conmemoración de su quinto centenario, este libro pretende rendir tributo a la primera vuelta al mundo (1519-1522), centrando su interés en l...
Ver todos los detalles€22,00| / -

EL HUERTO FAMILIAR ECOLÓGICO
Mariano Bueno€25,00| /Cultivar un huerto ecológico es algo más que obtener verduras, frutas y hortalizas de manera natural, ya que los frutos más preciados que se consig...
Ver todos los detalles€25,00| / -

FRUTOS Y PLANTAS SILVESTRES COMESTIBLES
TUNDRA€6,00| /Guía de bolsillo de introducción a los frutos y plantas silvestres comestibles de la península Ibérica, Baleares y Canarias, con láminas de identif...
Ver todos los detalles€6,00| / -

BIOLOGIA HUMANA.¡...A VER SI NOS ENTENDEMOS¡
SALVADOR FOJON POLANCO€26,60| /____ Editorial: Biblos 2019Idioma: Castellano
€26,60| / -

PARQUES NACIONALES DE ESPAÑA. 26 ITINERARIOS PARA DESCUBRIRLOS Y CONOCERLOS
Oriol Alamany, Eulàlia VicensPrecio original €42,00Precio actual €9,00| /Repleto de informaciones prácticas e ilustrado con hermosas fotografías, Parques Nacionales de España – 26 itinerarios para descubrirlos y conoce...
Ver todos los detallesPrecio original €42,00Precio actual €9,00| / -

LAS AVES MARINAS DE ESTACA DE BARES
Sandoval, Antonio€24,00| /Este libro sintetiza los resultados de miles de horas de censos de aves marinas desde Estaca de Bares durante varias décadas. Vuelan por sus págin...
Ver todos los detalles€24,00| / -

PARQUE NACIONAL MARITMO - TERRESTRE DE LAS ISLAS ATLÁNTICAS DE GALICIA
VV. AA.Precio original €42,00Precio actual €24,95| /Aquí está la mejor playa del mundo. Y no lo decimos nosotros, lo dice el periódico The Guardian. Es la playa de Rodas en las islas Cíes. Aguas cri...
Ver todos los detallesPrecio original €42,00Precio actual €24,95| / -

GUIA DE PLANTAS. PARQUE NATURAL DE AS FRAGAS DO EUME
Javier Guitián, José L.M. Villar€17,00| /Sus trece capítulos van desde los aspectos generales de la zona hasta las características de su patrimonio vegetal, cuya diversidad constituye una ...
Ver todos los detalles€17,00| / -

CETÁCEOS. INTRODUCCIÓN A LAS ESPECIES IBÉRICAS, BALEARES Y CANARIAS
Víctor J. Hernández€5,00| /DESPLEGABLE (21x60 cm), plastificado y resistenteNumerosas ilustraciones y fotografías a colorFormato: 21X10 cm. Numerosas ilustraciones y fotograf...
Ver todos los detalles€5,00| / -

LOS HONGOS
Elena Ibáñez, Miguel Herrero€12,00| /¿ Qué sabemos de...? Los hongos pertenecen a un reino de organismos con casi 100.000 especies conocidas. En los últimos años la micología ha experi...
Ver todos los detalles€12,00| / -

LAS PLANTAS QUE COMEMOS
Elena Ibáñez, Miguel Herrero€12,00| /En este libro se reflexiona y se ofrece información sobre las plantas en las que basamos nuestra alimentación. El autor presenta las especies vege...
Ver todos los detalles€12,00| / -

LAS ALGAS QUE COMEMOS
Elena Ibáñez, Miguel Herrero€12,00| /¿ Qué sabemos de...? Uno de los retos a los que se enfrenta la sociedad en el siglo XXI es el de ser capaz de alimentar a una creciente población m...
Ver todos los detalles€12,00| / -
 Agotado
Agotado
LAS PLANTAS SILVESTRES EN ESPAÑA
Ramón Morales€18,00| /Este libro pone de manifiesto la importancia del estudio de las plantes silvestres en España, concretamente las vasculares, las más evolucionadas, ...
Ver todos los detalles€18,00| /Agotado -

CONCHAS Y CARACOLAS DEL MUNDO
Osvaldo Negra, Giovanna Zobele Lipparini€35,00| /Guía ilustrada para una fácil identificación de las especies de mariscos y caracoles marinos más comunes del mundo. Más de 150 familias cubierta...
Ver todos los detalles€35,00| / -

CONCHAS MARINAS
S.P. Dance€37,70| /Con más de 500 especies ilustradas en color. Esta guía visual aporta todos los detalles necesarios para el coleccionista o aficionado a las conchas...
Ver todos los detalles€37,70| / -

A GRANDE ORQUESTRA ANIMAL
Bernie Krause€18,00| /Un canto apaixonado pola conservación dun dos recursos naturais máis esquecidos: a música da natureza. Con acceso a arquivos sonoros orixinais.Ilus...
Ver todos los detalles€18,00| / -

AVES MARINAS
Víctor J. Hernández€5,00| /DESPLEGABLE (21x60 cm), plastificado y resistenteNumerosas ilustraciones y fotografías a colorFormato: 21X10 cm. Guía de bolsillo de introducción a...
Ver todos los detalles€5,00| / -

CONCHAS Y CARACOLES MARINOS. INTRODUCCIÓN A LAS ESPECIES IBÉRICAS
Víctor J. Hernández€5,00| /DESPLEGABLE (21x60 cm), plastificado y resistenteNumerosas ilustraciones y fotografías a colorFormato: 21X10 cm. Guía de bolsillo de introducción a...
Ver todos los detalles€5,00| / -

¿QUIEN ALIMENTA REALMENTE AL MUNDO?
Vandana Shiva€19,00| /El fracaso de la agricultura industrial y la promesa de la agroecología. ¿Quién alimenta realmente al mundo? es un poderoso manifiesto que alza la...
Ver todos los detalles€19,00| / -

O LIBRO DOS OCÉANOS
Esther Gonstalla€21,50| /Cun deseño atractivo e informativo, e textos ben documentados, co apoio científico da German Ocean Foundation, un retrato detallado que nos permit...
Ver todos los detalles€21,50| / -

LUNARIO 2019
Michel Gros€8,90| /Calendario lunar para el huerto y el jardín ecológicos y para tu saludAprovecha la influencia lunar en el día a día. Trabaja en el jardín con la l...
Ver todos los detalles€8,90| /